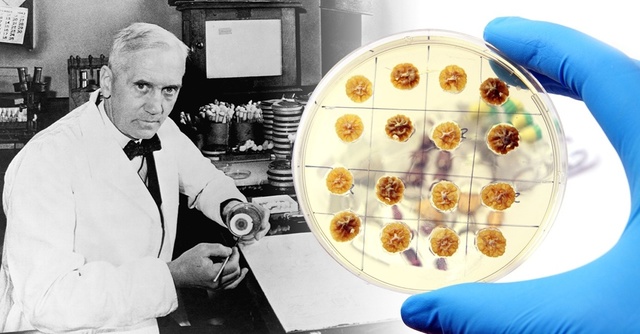
Alexander Fleming

-
franz fue uno de los primeros científicos en proteínas, y es famoso por sus estudios de sales que influyen en la solubilidad y la estabilidad conformacional de las proteínas . Hofmeister fue el primero en proponer que los polipéptidos eran aminoácidos unidos por enlaces peptídicos . aunque este modelo de estructura primaria de proteínas fue concebido de forma independiente y simultánea por Emil Fischer
-
propone el nombre de vitaminas para las sustancias organicas indispensables en cantidades minimas para mantener la vida. La existencia de una sustancia llamada vitamina (del latín vita : vida y amina: compuesto de nitrógeno) al estudiar que las poblaciones que consumían arroz integral tenían mayor resistencia o eran menos proclives a contraer beriberi; estan presentes en casi todos los alimentos.
-
Al describir el modo en que los genes se transmiten a través de los cromosomas, este cientifico aporto las bases físicas de la herencia confirmando las leyes de la herencia de Mendel y sentó las bases de la genética moderna.De sus estudios resultó una exposición compleja y convincente sobre, por un lado, el comportamiento de los cromosomas, y por otro sobre su morfología, con referencia a la transmisión y la modificación de los caracteres hereditarios.
-
Levene demostró que el DNA contenía otro azúcar de cinco carbonos, la desoxirribosa, que difería levemente de la ribosa. De esta manera, este ácido nucleico se llamó DNA (ácido desoxirribonucleico). Así, Levene demostró que el DNA está formado por desoxirribosa, un grupo fosfato y cuatro bases nitrogenadas: adenina y guanina (purinas) y timina y citosina (pirimidinas).
-
científico sostiene que la vida comenzó su existencia a partir de una materia inerte, que en algún momento del período comprendido entre 4.400 millones de años y 2.700 millones, produjo los primeros indicios de vida.El origen de la vida en el planeta tierra o la abiogénesis, como también se denomina a la mencionada cuestión, ha sido un tema de estudio especializado y profundo, por parte de las ciencias de la naturaleza, desde hace muchísimos años; ¿cómo? y ¿cuándo surgió la vida?
-
Cuando revisaba sus cultivos viejos de bacterias, encontró en uno de ellos una mancha azul verdosa, la cual crecía donde estaba una bacteria peligrosa. La mancha parecía que estaba matando a la bacteria. Empezó una serie de experimentos de la mancha ,que resultó ser el hongo penicilliu; este hongo produce una sustancia llamada penicilina que tiene la capacidad de matar algunos tipos de bacterias sin causar daño a las heridas ni daño a las personas que se les administraba.
-
Demostró que los genes pueden desplazarse: Sus innovadores resultados llegaron de la mano de una planta muy utilizada en investigación y en nuestra alimentación diaria: el maíz. Estudiando su genoma, es decir, observando las miles de “letras” que componen su ADN, vio por primera vez que existía una serie de secuencias genéticas que podían, de alguna extraña manera, cambiar su posición.
-
A mediados del siglo XX aún estaba sin desvelar el gran enigma que guardaba la clorofila en la alimentación y crecimiento de las plantas. La física nuclear permitió desvelar el secreto de la naturaleza, calvin consiguió averiguar como sucedía esto, el método que utilizo fue marcar con el isótopo radiactivo dando así la ruta química de la fotosíntesis.
-
Descubrieron que la estructura del ADN era una doble hélice, formada por dos cadenas complementarias de nucleótidos,cada una orientada en dirección opuesta. Esta afrimacion se basó en su representación de fotografías de difracción de rayos X. la complementaridad era altamente especifica: el apareamiento de la adenina,que es una purina, con la timina que es una pirimidina,resulto ser correcta.
-
Junto con Marianne Grunberg-Manago, su trabajo dio lugar al descubrimiento de un nuevo enzima, la polinucleótido fosforilasa, capaz de sintetizar in vitro ácido ribonucleico (RNA). Este trabajo le valió a Ochoa el Premio Nobel de Fisiología o Medicina en 1959. El uso de la polinucleótido fosforilasa fue esencial en el desciframiento del código genético.
-
Estudió la poliomielitis y el desarrollo de una vacuna contra la enfermedad que se extendió por todo el mundo en la década de los años sesenta y setenta ;Sabin persistió en el empeño de crear una vacuna a base de virus vivos o atenuados que pudiera administrarse por vía bucal, que fuera trivalente, y que produjera una protección más duradera. Un hecho importante que debe destacarse es que Sabin nunca quiso patentar la vacuna. Insistió en que ésta debía de aplicarse de forma gratuita.
-
Realizaron estudios sobre el control genético de la síntesis de enzimas,el cual es abarcado por un esquema general, en el que se incluye la existencia de la molecula clave para la conexión entre la información genética y la estructura de las proteínas, además este esquema de síntesis proteica generaliza la idea del represor como producto génico cuyo objetivo es el control de la expresión de otros genes.
-
El virus del sida (VIH) ha producido la muerte de más de 25 millones de personas, gracias a la investigación iniciada y su descubrimiento, el conocimiento de su modo de transmisión y forma de atacar a las células ha permitido tomar medidas preventivas y desarrollar terapias con antirretrovirales que proporcionan a las personas infectadas una esperanza de vida. La obtención de la vacuna antisida es uno de los retos de la investigación biomédica.
-
Entre sus principales aportes, se encuentran el haber participado en la creación de la vacuna contra el virus de la hepatitis B, el descubrimiento del virus de la hepatitis C y el desarrollo de un proceso para producir insulina humana a partir de levaduras; además, bajo su dirección, científicos clonaron y secuenciaron el virus del sida.
-
Dolly la oveja,primer mamífero en ser clonado de una célula adulta se toma una célula y de ella se extrae el núcleo que contiene todos los cromosomas se detiene el reloj biológico de la célula mamaria para que se olvide su función anterior. De otra oveja se toma un óvulo no fecundado, del cual se elimina el núcleo porque contiene solo la mitad de los cromosomas, Se combinan el citoplasma y el núcleo. Este último tiene toda la herencia (ADN) de la oveja madre, por eso el clon será igual
-
Se publica el mapa provisional del genoma humano.El genoma humano es el genoma del Homo sapiens, es decir, la secuencia de ADN contenida en 23 pares de cromosomas en el núcleo de cada célula humana diploide.La secuencia de ADN que conforma el genoma humano contiene la información codificada, necesaria para la expresión, altamente coordinada y adaptable al ambiente, del proteoma humano, es decir, del conjunto de las proteínas del ser humano.
-
Descubrió la forma de transformar células
totipotentes, en cualquier tipo de tejido.Obtuvieron células madre a partir de células de piel humana. Con ayuda de un virus, los investigadores integraron en el ADN de la piel las proteínas que regulan la actividad de los genes y determinan el cambio de tipo de célula. Como resultado de la modificación genética obtuvieron las células madre. -
Cirujanos del Hospital Vall d’Hebron de Barcelona, España, dirigidos por Juan Barret llevaron a cabo por primera vez un trasplante de cara completa. La operación duró un día y en ella participación más de 30 médicos. El paciente recibió de un donante músculos faciales, huesos de la mandíbula, piel, nariz, labios, mandíbula, dientes y garganta, por lo que se realizó un trasplante de cara completa.
-
proteinas indispensables para células madre, se identifico dos proteínas indispensables para preservar las células madre de la piel,las proteínas identificadas Dnmt3a y Dnmt3b,son especiales para la auto-renovacion de las células madre de la piel.
-
El químico David Liu, de la Universidad de Harvard, ha modificado la caja de herramientas de CRISPR para crear un editor de bases mucho más precisa que la versión original de la técnica, puede manipular letras individuales del genoma para cambiar una A por una G y viceversa. Gracias a ella podrían repararse unas 15.000 mutaciones puntuales asociadas a enfermedades.
A list shows items. A timeline shows sequence.
Use Timetoast to make dates, milestones, and turning points easier to understand in a clear visual format. Timetoast is a timeline maker for work, school, research, and stories.